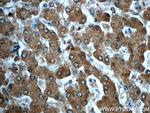
ADH7 Antibody in Immunohistochemistry (Paraffin) (IHC (P))

Search
Proteintech
ADH7 Polyclonal Antibody
{{$productOrderCtrl.translations['antibody.pdp.commerceCard.promotion.promotions']}}
{{$productOrderCtrl.translations['antibody.pdp.commerceCard.promotion.viewpromo']}}
{{$productOrderCtrl.translations['antibody.pdp.commerceCard.promotion.promocode']}}: {{promo.promoCode}} {{promo.promoTitle}} {{promo.promoDescription}}. {{$productOrderCtrl.translations['antibody.pdp.commerceCard.promotion.learnmore']}}
产品信息
23425-1-AP
种属反应
宿主/亚型
分类
类型
抗原
偶联物
形式
浓度
规格
纯化类型
保存液
内含物
保存条件
运输条件
产品详细信息
Immunogen sequence: ISPKDSTKP ISEVLSEMTG NNVGYTFEVI GHLETMIDAL ASCHMNYGTS VVVGVPPSAK MLTYDPMLLF TGRTWKGCVF GGLKSRDDVP KLVTEFLA (253-349 aa encoded by BC131512)
靶标信息
This gene encodes class IV alcohol dehydrogenase 7 mu or sigma subunit, which is a member of the alcohol dehydrogenase family. Members of this family metabolize a wide variety of substrates, including ethanol, retinol, other aliphatic alcohols, hydroxysteroids, and lipid peroxidation products. The enzyme encoded by this gene is inefficient in ethanol oxidation, but is the most active as a retinol dehydrogenase; thus it may participate in the synthesis of retinoic acid, a hormone important for cellular differentiation. The expression of this gene is much more abundant in stomach than liver, thus differing from the other known gene family members.
仅用于科研。不用于诊断过程。未经明确授权不得转售。
篇参考文献 (0)
生物信息学
蛋白别名: Alcohol dehydrogenase class 4 mu/sigma chain; Alcohol dehydrogenase class IV mu/sigma chain; alcohol dehydrogenase VII; alcohol dehydrogenase-7; All-trans-retinol dehydrogenase [NAD(+)] ADH7; class IV sigma-1 alcohol dehydrogenase; class IV sigmasigma alcohol dehydrogenase; Gastric alcohol dehydrogenase; Omega-hydroxydecanoate dehydrogenase ADH7; ret; Retinol dehydrogenase; unnamed protein product
基因别名: ADH4; ADH7
UniProt ID: (Human) P40394
Entrez Gene ID: (Human) 131